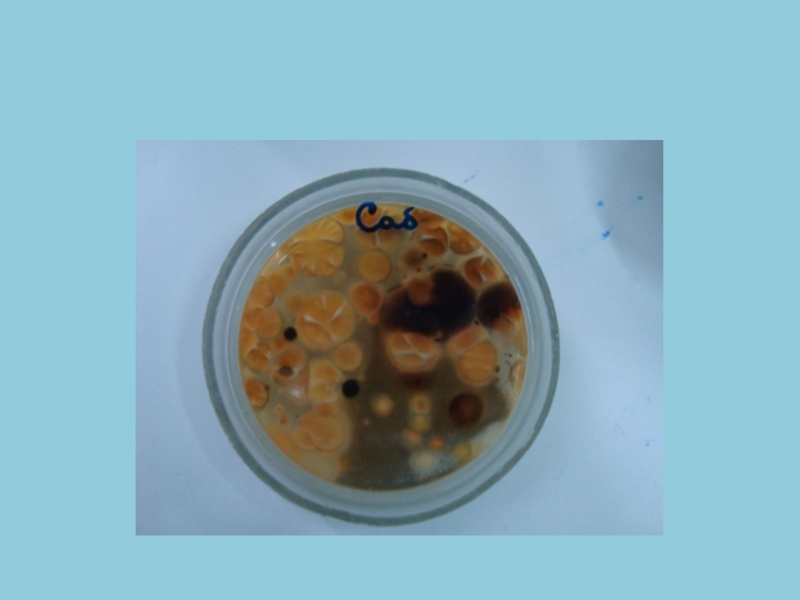

Разделы презентаций
- Разное
- Английский язык
- Астрономия
- Алгебра
- Биология
- География
- Геометрия
- Детские презентации
- Информатика
- История
- Литература
- Математика
- Медицина
- Менеджмент
- Музыка
- МХК
- Немецкий язык
- ОБЖ
- Обществознание
- Окружающий мир
- Педагогика
- Русский язык
- Технология
- Физика
- Философия
- Химия
- Шаблоны, картинки для презентаций
- Экология
- Экономика
- Юриспруденция
Микология поверхностных и глубоких микозов
Содержание
- 1. Микология поверхностных и глубоких микозов
- 2. План лекции1. микозы – характеристика2. классификация3.особо опасные микозы4.Часто встречающийся микоз(кандидоз)
- 3. Микозы (от греч. mykes — гриб)–
- 4. Споры грибков попадают в кожу, подкожную клетчатку
- 5. 20% населения всего мира, т. е. каждый пятый житель нашей планеты, поражен грибковой инфекцией
- 6. Все грибы можно разделить на два
- 7. Особо патогенны для человека облигатно-патогенные грибы:
- 8. Слайд 8
- 9. Основные возбудители микозов:Дрожжеподобные грибы Candina, Плесневые грибы Aspergillus, Penicillium, Scopulariopsis, Mucor, Cephalosporium, Alternaria и др.
- 10. Возбудители микотических инфекций:I. Возбудители глубоких
- 11. Пути зараженияпрямой путь передачи инфекции имеет место
- 12. Патогенез микотического поражения:Адгезия к клеткам слизистой оболочкиКолонизацияИнвазивный
- 13. Факторы риска развития микозов:Иммунодефицитные состояния (онкология, широкое
- 14. Факторы защиты от грибовЦелостные, нормально функционирующие пограничные
- 15. Основными механизмами нарушения
- 16. Классификация. В основу классификации грибковых заболеваний человека положена глубина поражения и возбудитель. Выделяют четыре группы дерматомикозов.
- 17. 1. Кератомикозы (отрубевидный лишай).2. Дерматофитии (микроспория,
- 18. Поверхностные микозыКератомикозы- поражают только роговой слой кожи. Хроническое
- 19. Заболеваемость микозами кожи и ее придатков в настоящее время
- 20. Эритразма Это псевдомикоз, возбудители - коринобактерии (Corynebactenum
- 21. В местах поражения образуются пятна розово-красного
- 22. Патогенез эритразмыусиленное потоотделение, себорея, а также некоторые
- 23. Микробиологическая диагностика.Основным методом выявления разноцветного лишая является
- 24. Лечениефунгицидные препараты (наружные)Применяют аэрозольные соединения (клотримазол, кетоконазол, климбазол) в форме шампуня, крема или раствора.
- 25. профилактикаисключение близкого контакта с больным (осмотр членов
- 26. Дерматомикозы К группе дерматомикозов относятся микроспория, трихофития
- 27. МикроспорияЯвляется высококонтагиозным заболеванием, которое поражает кожу и
- 28. Слайд 28
- 29. Микоз волосистой части головы Микроспория волосистой части
- 30. диагностикаКлинический диагноз микроспории волосистой части головы подтверждают
- 31. Диагноз микроспории гладкой кожи подтверждается на основании
- 32. Трихофития Представляет контагиозное заболевание человека и животных,
- 33. Пути передачиПередача заболевания может осуществляться и косвенно
- 34. Выделяют две основные группы: эндотрикс (грибы, которые
- 35. Эктотриксы – зоофилы, паразитирующие преимущественно на животных,
- 36. По клиническим проявлениям трихофитию можно разделить на три группы: поверхностную, хроническую инфильтративно-нагноительную.
- 37. клиникаИзмененные в цвете, тусклые, серые, утолщенные волосы
- 38. Хроническая форма трихофития часто длится долгие годы
- 39. микологическое исследование (микроскопия и культуральная диагностика).
- 40. лечениеК противогрибковым препаратам общего действия при микроспории
- 41. Профилактические мероприятия1) регулярные осмотры детей в детских
- 42. Противоэпидемические мероприятияпри микроспории включают борьбу с бродячими
- 43. Фавус Это редкое хроническое грибковое заболевание кожи
- 44. Заболевание чаще локализуется на волосистой части головы, реже поражаются ногти и гладкая кожа.Формы:скутулярную (типичную), питириоидную импетигинозную.
- 45. Нелеченый фавус течет многие годы. Поражения внутренних
- 46. диагностикаДиагноз фавуса ставится на основании характерной клинической
- 47. Микоз стоп занимает одно из первых
- 48. Заражение происходит чаще всего в банях,
- 49. устойчивостьВозбудители крайне устойчивы в окружающей среде: могут
- 50. . Микоз стоп обычно рецидивирует весной и осенью и может привести к временной потере трудоспособности.
- 51. экзогенные факторыпотертости, повышенная потливость стоп, которая усиливается
- 52. Эндогенные факторынарушение микроциркуляции в нижних конечностях (при
- 53. Микологическое исследованиеобнаружения мицелия и получения культуры гриба).
- 54. лечениенаружная терапия веществами с фунгицидной активностью и широким спектром действия: азолы, аллиламины, производные циклопирокса и аморолфина.
- 55. Микоз кистейвозбудителем является красный трихофитон, реже –
- 56. Микоз гладкой кожи Наиболее частым возбудителем микоза
- 57. микозы гладкой кожиФормы:эритемато-сквамозную, фолликулярно-узелковую инфильтративно-нагноительную.
- 58. Очаги поражения могут наблюдаться и на тыле
- 59. Эритемато-сквамозная форма микозаКрасные шелушащиеся пятна круглой или
- 60. Фолликулярно-узелковая форма микозаотличается сгруппированными пустулезными и папуло-пустулезными
- 61. Инфильтративно-нагноительная форма микозанагноительная трихофития, вызванная зоофильными трихофитонами.
- 62. Онихомикоз Это грибковое поражение ногтевой пластинки. Изолированное инфицирование ногтевых пластинок грибами наблюдается редко.
- 63. патогенез онихомикозаОсновная роль в нарушении кровообращения в
- 64. Изменение цвета, поверхности и
- 65. Диагноз онихомикоза ставят на основании характерной клинической
- 66. КандидозКандидоз – это заболевание кожи, ногтей и
- 67. факторыК эндогенным :эндокринные заболевания, тяжелые общие заболевания
- 68. Инфицированиепроисходит в родовых путях, вместе с этим
- 69. Дисбактериоз и нарушение защитной системы слизистой оболочки
- 70. разновидности кандидоза: 1) поверхностный кандидоз (рта, гениталий, кожи,
- 71. Поверхностный кандидозПо локализации поражения различают:1) кандидоз слизистых
- 72. Хронический гиперпластический кандидозвозникает при длительной колонизации дрожжеподобных грибов. Чаще на слизистой полости рта.
- 73. Хронический атрофический кандидозвозникает у лиц, носящих съемный
- 74. диагностикаПри микроскопии нативных или окрашенных анилиновым красителем
- 75. Лабораторная диагностикаосложнена тем, что структура грибков значительно
- 76. Микробиологическое исследованиеМикроскопическоеКультуральноеЕсли получены нечеткие результаты при микроскопии
- 77. микроскопия
- 78. Культуральный метод
- 79. Культуральный методДля выделения грибковых культур являются
- 80. Слайд 80
- 81. Слайд 81
- 82. Культуры грибков исследуют в динамике, определяя цвет,
- 83. предрасполагающие факторы:иммунодефицитное состояние, болезнь крови, новообразованиедисбактериоз кишечника, и др.
- 84. Глубокие микозыГрибы, вызывающие глубокие микозы, диморфные: во
- 85. Глубокие микозы распространены в регионах с тропическим и субтропическим климатом.
- 86. К опасным глубоким микозам, вызывающим тяжелые поражения кожи, слизистых- кокцидиоидоз гистоплазмоз,
- 87. диагностикаНаиболее информативны положительные результаты нескольких серологических реакций
- 88. Актиномикоз Болезнь вызывается несколькими видами актиномицетов. Наряду
- 89. диагностикаДля выделения анаэробных лучистых грибков (актиномицетов) используется
- 90. Слайд 90
- 91. лечение микозовСамостоятельное лечение микозов крайне нежелательно и
- 92. лечениеантимикотики в сочетании с наружной противогрибковой терапией.
- 93. Профилактикаосторожно разбирать старые и ветхие строения;проявлять осторожность
- 94. выводыМикозы (грибковые заболевания) – обширная группа поражений
- 95. Особо патогенны для человека облигатно-патогенные грибы, которые
- 96. Спасибо за внимание!
- 97. Скачать презентанцию
План лекции1. микозы – характеристика2. классификация3.особо опасные микозы4.Часто встречающийся микоз(кандидоз)
Слайды и текст этой презентации
Слайд 2План лекции
1. микозы – характеристика
2. классификация
3.особо опасные микозы
4.Часто встречающийся микоз(кандидоз)
Слайд 3
Микозы (от греч. mykes — гриб)– широко распространенная группа
инфекций, вызванных большим числом видов ( более 400 ) различных
патогенных и условно патогенных грибовОни поражают человека, домашних и диких животных, птиц, насекомых, земноводных, рыб, растения.
Источником инфекции являются среда, животные, люди.
Слайд 4
Споры грибков попадают в кожу, подкожную клетчатку в результате микротравм,
оседают на слизистых оболочках глаз и верхних дыхательных путей или
в легких при дыхании. Развитию микозов способствуют снижение защитных сил организма.Слайд 5
20% населения всего мира, т. е. каждый пятый житель нашей
планеты, поражен грибковой инфекцией
Слайд 6
Все грибы можно разделить на два большие группы:
облигатно-патогенные
грибы (около 30 видов)
условно-патогенные (плесневые грибы: мукоры, Конидии Aspergillus
fumigatus Слайд 7
Особо патогенны для человека облигатно-патогенные грибы: (22 вида трихофитонов,
16 видов микроспорумов и 1 вид эпидермофитона).
Слайд 8
Плесени и органы
плодоношения некоторых плесневых грибов:
1- пенициллиум;
2 - аспергиллус;
3-
мукорПлесени и органы плодоношения некоторых плесневых грибов:
1- пенициллиум;
2 - аспергиллус;
3- мукор
Слайд 9Основные возбудители микозов:
Дрожжеподобные грибы Candina,
Плесневые грибы Aspergillus,
Penicillium,
Scopulariopsis,
Mucor,
Cephalosporium,
Alternaria и др.
Слайд 10Возбудители микотических инфекций:
I. Возбудители глубоких (системных) микозов: Coccidioides
immitis, Histoplasma
II. Возбудители capsulatum, Criptococcus neoformans,
Blastomyces dermatitidis.и подкожных (субкутанных) микозов: Sportrichum schenckii и др.
III. Возбудители эпидермомикозов (дерматомикозов): canis, Trichophyton rubrum и др.
IV. Возбудители кератомикозов (поверхностных микозов): Malassezia furfur,
Cladosporium werneskii, Trichosporon cutaneum и др.
V. Возбудители оппортунистических микозов: Candida albicans; различные виды родов Aspergillus, Mucor, Penicillium и др.
Слайд 11Пути заражения
прямой путь передачи инфекции имеет место при контакте с
почвой, растениями, больным животным или больным человеком;
непрямой – при
соприкосновении с различными вещами и предметами, бывшими употреблении у больного, а также через предметы ухода за животными.Слайд 12Патогенез микотического поражения:
Адгезия к клеткам слизистой оболочки
Колонизация
Инвазивный рост
Генерализация процесса
Возникновением вторичных
очагов микозов в различных органах и тканях.
Слайд 13Факторы риска развития микозов:
Иммунодефицитные состояния (онкология, широкое применение антибиотиков, кортикостероидных
препаратов, цитостатиков)
Физиологические иммунодефициты - период новорожденности, старческий возраст, беременность, стресс.
Нарушения обмена веществ, СД
Травмы, операции
Условия труда
Хроническое воспаление
Слайд 14Факторы защиты от грибов
Целостные, нормально функционирующие пограничные ткани (кожные и
слизистые покровы)
Многослойное строение эпителия кожи с наличием
постоянно обновляющего рогового слояАнтифунгальные свойства кожи
Кислый характер среды
Наличие представителей микрофлоры – основных антагонистов грибов (колонизационный иммунитет).
Лизоцим, секреторные иммуноглобулины – антитела, относящиеся к IgA на слизистых.
Факторы специфического и неспецифического иммунитета.
Слайд 15
Основными механизмами нарушения защитных реакций хозяина
является их способность к подавлению защитной активности фагоцитов и нарушение
процессов формирования специфического иммунитета.Слайд 16Классификация.
В основу классификации грибковых заболеваний человека положена глубина поражения и
возбудитель.
Выделяют четыре группы дерматомикозов.
Слайд 17
1. Кератомикозы (отрубевидный лишай).
2. Дерматофитии (микроспория, трихофития поверхностная, трихофития
хроническая, трихофития инфильтративно-нагноительная, фавус, микоз стоп, микоз гладкой кожи, микоз
паховых складок, онихомикоз).3. Кандидоз (кандидоз поверхностных слизистых оболочек, кожи, ногтевых валиков и ногтей, кандидоз хронический генерализованный (гранулематозный), кандидоз висцеральный).
4. Глубокие микозы (кокцидиодоз, гистоплазмоз, бластомикозы, споротрихоз, хромомикоз, кладоспоридоз, пенициллез, аспергиллез).
Слайд 18Поверхностные микозы
Кератомикозы- поражают только роговой слой кожи.
Хроническое течение, едва заметные
воспалительные явления.
Выделяют заболевания:
• разноцветный (отрубевидный) лишай
• эритразма
Слайд 19
Заболеваемость микозами кожи и ее придатков в настоящее время принимает эпидемический характер.
По данным ВОЗ, каждый пятый житель нашей планеты имеет данную
патологию. Слайд 20Эритразма
Это псевдомикоз, возбудители - коринобактерии (Corynebactenum minutissimum). Локализуется на коже
в области крупных складок, пахово-бедренных, под грудными железами
Слайд 21
В местах поражения образуются пятна розово-красного цвета, овальной формы,
с резкими границами.
Иногда беспокоит зуд. У детей, особенно раннего
возраста, заболевание наблюдается редко. У подростков, помимо обычной локализации, эритразма порой обнаруживается в межпальцевых складках стоп.
Слайд 22Патогенез эритразмы
усиленное потоотделение, себорея, а также некоторые эндокринные расстройства, например
синдром Иценко – Кушинга, сахарный диабет
Заболевание встречается чаще в регионах
с жарким климатом и повышенной влажностью.Слайд 23Микробиологическая диагностика.
Основным методом выявления разноцветного лишая является проба Бальзера( смазывание
кожи 5%-ным раствором йода) считается положительной при более темном окрашивании
очагов поражения.В лучах люминесцентной лампы очаги поражения светятся золотисто-желтым цветом.
микроскопическое исследование чешуек с очагов поражения (короткий, широкий, изогнутый псевдомицелий и одиночные или расположенные гроздьями крупные споры).
Слайд 24Лечение
фунгицидные препараты (наружные)
Применяют аэрозольные соединения (клотримазол, кетоконазол, климбазол) в форме
шампуня, крема или раствора.
Слайд 25профилактика
исключение близкого контакта с больным (осмотр членов семьи), а также
обработка нательного и постельного белья (кипячение) в процессе лечения. На
этапе реконвалесценции назначают один из современных противогрибковых препаратов 1 раз в месяц (например, шампуни с азолами.Слайд 26Дерматомикозы
К группе дерматомикозов относятся микроспория, трихофития и фавус.
паразитируют на человеке
и животных.
У людей дерматофиты поражают в основном эпидермис (чаще роговой
слой), а также придатки кожи – волосы (микроспорумы и трихофитоны) ногти (трихофитоны и эпидермофитоны).
Слайд 27Микроспория
Является высококонтагиозным заболеванием, которое поражает кожу и волосы и вызывается
различными видами грибов.
Инкубационный период при микроспории около 2 – 4
дней. Первым признаком вид подстриженных волос.
Слайд 29Микоз волосистой части головы
Микроспория волосистой части головы, обусловленная ржавым
микроспорумом,
С большим количеством очагов и склонностью к их слиянию,
с поражением волосистой части головы и гладкой кожи лица и шеи.Слайд 30диагностика
Клинический диагноз микроспории волосистой части головы подтверждают положительными результатами микроскопического
исследования волос, получением культуры возбудителя и отчетливым зеленым свечением пораженных
волос при люминесцентном исследовании.Слайд 31
Диагноз микроспории гладкой кожи подтверждается на основании обнаружения мицелия и
спор в кожных чешуйках с очагов поражения и культурального исследования.
Слайд 32Трихофития
Представляет контагиозное заболевание человека и животных, которое вызывается различными видами
грибов и поражает кожу, волосы и ногти.
Возбудители трихофитии подразделяют на
группы в зависимости от типа поражения волос. Слайд 33Пути передачи
Передача заболевания может осуществляться и косвенно – через предметы
и вещи, которые были в соприкосновении с больным.
Слайд 34
Выделяют две основные группы:
эндотрикс (грибы, которые поражают внутреннюю часть
волоса) и
эктотрикс (вегетирующие преимущественно в наружных слоях волоса).
Все трихофитоны
из группы эндотриксов – антропофилы, передающиеся только от человека к человеку. Они вызывают поверхностные поражения кожи, волосистой части головы, а также ногтей.Слайд 35
Эктотриксы – зоофилы, паразитирующие преимущественно на животных, но способные поражать
также и человека. По сравнению с грибами группы эндотрикс они
вызывают у человека более выраженную воспалительную реакцию кожи.Слайд 36
По клиническим проявлениям трихофитию можно разделить на три группы:
поверхностную,
хроническую
инфильтративно-нагноительную.
Слайд 37клиника
Измененные в цвете, тусклые, серые, утолщенные волосы при трихофитии, в
отличие от микроспории, обламываются на разных уровнях и не все.
Наряду с коротко обломанными (2 – 3 мм), в очагах обнаруживают на вид неизмененные, длинные волосы
Ногтевые пластинки при поверхностной трихофитии поражаются крайне редко.
Слайд 38
Хроническая форма трихофития часто длится долгие годы и имеет скудные
клинические проявления. Они с трудом выявляются, и поэтому заболевание долго
не диагностируется.При инфильтративно-нагноительной трихофитии на волосистой части головы, а у мужчин также в области роста бороды и усов появляются один или два резко ограниченных воспалительных узла, выступающих над поверхностью кожи и болезненных при пальпации.
Слайд 40лечение
К противогрибковым препаратам общего действия при микроспории и трихофитии относятся
гризеофульвин, тербинафин (ламизил, экзифин), итраконазол (орунгал), флуконазол (дифлюкан, микосист) и
кетоконазол (низорал).Слайд 41Профилактические мероприятия
1) регулярные осмотры детей в детских учреждениях и лиц,
которые обслуживают эти коллективы;
2) выявление источников заражения;
3) изоляцию и госпитализацию
больных;4) дезинфекцию вещей, которыми пользовался больной;
5) диспансеризацию больных;
6) наблюдение за парикмахерскими;
7) ветеринарный надзор за животными;
8) профилактические осмотры детей, поступающих в детские учреждения и возвращающихся с каникул;
9) санитарно-просветительную работу.
Слайд 42Противоэпидемические мероприятия
при микроспории включают борьбу с бродячими кошками, ветеринарный надзор
за домашними кошками и собаками, поскольку большинство заражений происходит от
этих животных.Учитывая возможность инфицирования детей друг от друга путем прямого контакта, а также через предметы (головные уборы, расчески, полотенца), следует проводить осмотры школьников не реже 2 раз в год.
Слайд 43Фавус
Это редкое хроническое грибковое заболевание кожи и ее придатков, вызываемое
антропофильным грибом.
В развитии болезни имеют значение хронические инфекции, авитаминоз, эндокринопатии.
Заболевание начинается в детском возрасте, но поскольку ему не свойственно самоизлечение, обнаруживается и у взрослых.
Слайд 44
Заболевание чаще локализуется на волосистой части головы, реже поражаются ногти
и гладкая кожа.
Формы:
скутулярную (типичную),
питириоидную
импетигинозную.
Слайд 45
Нелеченый фавус течет многие годы. Поражения внутренних органов наблюдаются очень
редко, в основном у истощенных и лиц, которые страдают туберкулезной
инфекцией. Известны поражения желудочно-кишечного тракта, легких, фавозный лимфаденит, фавозный менингоэнцефалит.Слайд 46диагностика
Диагноз фавуса ставится на основании характерной клинической картины, характерного свечения
(тусклого зеленоватого) пораженных волос при освещении люминесцентной лампой с фильтром
Вуда,микроскопического исследования пораженных волос
получения культуры возбудителя.
Слайд 47
Микоз стоп занимает одно из первых мест среди болезней
кожи.
Под микозом стоп понимают поражение кожи, вызываемое некоторыми дерматофитными
и дрожжевыми грибами, имеющее общую локализацию и сходные клинические проявления. Слайд 48
Заражение происходит чаще всего в банях, душевых, плавательных бассейнах,
спортивных залах при недостаточном соблюдении санитарно-гигиенических правил их содержания, а
также на пляжах при контакте кожи стоп с загрязненными чешуйками песком.Слайд 49устойчивость
Возбудители крайне устойчивы в окружающей среде:
могут расти на древесине,
стельках обуви, длительно сохраняются в носках, чулках, перчатках, на полотенцах,
а также на предметах банного оборудованияСлайд 50
. Микоз стоп обычно рецидивирует весной и осенью и может
привести к временной потере трудоспособности.
Слайд 51экзогенные факторы
потертости, повышенная потливость стоп, которая усиливается при ношении носков
из синтетических волокон, тесной, не по сезону теплой обуви и
приводит к мацерации рогового слоя на стопах.Слайд 52Эндогенные факторы
нарушение микроциркуляции в нижних конечностях (при атеросклерозе, облитерирующем эндоартериите,
варикозном расширении вен нижних конечностей, вегетативном дисбалансе, симптоме Рейно), гиповитаминоза,
иммуносупрессией врожденной или приобретенной (например, при ВИЧ-инфекции, приеме глюкокортикостероидов, цитостатических, антибактериальных, эстроген-гестагенных препаратов, иммуносупрессантов).Слайд 54лечение
наружная терапия веществами с фунгицидной активностью и широким спектром действия:
азолы, аллиламины,
производные циклопирокса и аморолфина.
Слайд 55Микоз кистей
возбудителем является красный трихофитон, реже – другие другие дерматофиты.
Большую
роль в возникновении микоза кистей играют травмы и нарушение микроциркуляции
в области дистальных отделов верхних конечностей (при атеросклерозе, синдроме Рейно), а также эндокринные нарушения и иммуносупрессивные состояния.Слайд 56Микоз гладкой кожи
Наиболее частым возбудителем микоза гладкой кожи является красный
трихофитон.
Его генерализации способствуют гормональные нарушения,
приобретенные иммунодефицитные состояния, а также
расстройства рогообразования, возникающие при ихтиозе, кератодермии и гиповитаминозе А.Слайд 57микозы гладкой кожи
Формы:
эритемато-сквамозную,
фолликулярно-узелковую
инфильтративно-нагноительную.
Слайд 58
Очаги поражения могут наблюдаться и на тыле кистей в виде
участков синюшной эритемы с фестончатыми или овальными очертаниями.
Края очагов
прерывистые и состоят из узелков, пузырьков, корочек. Поражение ладоней может сочетаться с онихомикозом кистей.Диагностика, лечение и профилактика аналогичны таковым при микозе стоп.
Слайд 59Эритемато-сквамозная форма микоза
Красные шелушащиеся пятна круглой или овальной формы, которые
имеют склонность к периферическому росту, сливаются и образуют очаги полициклических
очертаний с отечным, вишнево-красного цвета прерывистым периферическим валиком, состоящим из фолликулярных папул и пустул.Слайд 60Фолликулярно-узелковая форма микоза
отличается сгруппированными пустулезными и папуло-пустулезными высыпаниями, которые не
обламываются и по внешнему виду мало отличаются от здоровых.
Слайд 61Инфильтративно-нагноительная форма микоза
нагноительная трихофития, вызванная зоофильными трихофитонами.
На месте очагов
после их разрешения остаются атрофия или отдельные рубчики.
Слайд 62Онихомикоз
Это грибковое поражение ногтевой пластинки.
Изолированное инфицирование ногтевых пластинок грибами
наблюдается редко.
Слайд 63патогенез онихомикоза
Основная роль в нарушении кровообращения в конечностях.
функциональные и органические
заболевания нервной системы, приводящие к нарушению трофики тканей,
эндокринные заболевания,
иммунодефицитные состояния, некоторые хронические кожные заболевания,
расстройства рогообразования и дистрофии ногтевых пластинок.
механическая и химическая травмы ногтевых пластинок отморожение и ознобление.
Слайд 64
Изменение цвета, поверхности и формы ногтевых пластинок.
Ногтевой валик не поражается.
Подногтевой гиперкератоз приобретает желтоватую окраску, крошится, края
ее становятся зазубренными.Атрофическая форма онихомикоза характеризуется значительным истончением, отслоением ногтевой пластинки от ногтевого ложа, образованием пустот или частичным ее разрушением.
Слайд 65
Диагноз онихомикоза ставят на основании характерной клинической картины и лабораторных
данных. микроскопическое исследование пораженных ногтевых чешуек и получения культуры гриба.
Слайд 66Кандидоз
Кандидоз – это заболевание кожи, ногтей и слизистых оболочек, иногда
– внутренних органов, вызываемое дрожжеподобными грибами.
Наиболее подвержены этому заболеванию младенцы,
очень старые и очень больные люди. Слайд 67факторы
К эндогенным :
эндокринные заболевания, тяжелые общие заболевания (лимфома, лейкемия, ВИЧ-инфекция),
патологически протекающая беременность.
применение антибиотиков с широким спектром антибактериального действия,
глюкокортикостероидов, цитостатиков,
гормональная контрацепция.
Слайд 68Инфицирование
происходит в родовых путях, вместе с этим доказана также возможность
трансплацентарного пути заражения (врожденный кандидоз).
Возникновение кандидоза у взрослых чаще
всего связано с аутогенным суперинфицированием, но может иметь место и экзогенное инфицирование генитальной, Слайд 69
Дисбактериоз и нарушение защитной системы слизистой оболочки и кожи облегчает
прикрепление (адгезию) гриба к эпителиоцитам и проникновение его через эпителиальный
барьер.Слайд 70разновидности кандидоза:
1) поверхностный кандидоз (рта, гениталий, кожи, ногтевых валиков и
ногтей);
2) хронический генерализованный (гранулематозный) кандидоз у детей и подростков;
3) хронический
кожно-слизистый кандидоз;4) висцеральный кандидоз (поражение различных внутренних органов и систем: кандидоз глотки, пищевода и кишечника, кандидоз бронхов и легких).
Данные изменения сопровождаются ощущениями сухости слизистой и жжением, иногда выраженной болезненностью.
Слайд 71Поверхностный кандидоз
По локализации поражения различают:
1) кандидоз слизистых оболочек и кожи
(кандидозный стоматит, кандидозный глоссит, кандидоз углов рта, кандидозный хейлит, кандидозный
вульвовагинит, кандидозный баланопостит);2) кандидоз кожи и ногтей (кандидоз больших складок, кандидозные паронихии и онихии).
Наиболее частой клинической формой острого кандидоза является молочница, или псевдомембранозный кандидоз. Он часто возникает у новорожденных в первые 2 – 3 недели жизни и у взрослых с перечисленными выше предрасполагающими факторами.
Слайд 72Хронический гиперпластический кандидоз
возникает при длительной колонизации дрожжеподобных грибов.
Чаще на
слизистой полости рта.
Слайд 73Хронический атрофический кандидоз
возникает у лиц, носящих съемный пластмассовый протез верхней
челюсти. Слизистая оболочка протезного ложа гиперимирована, местами эрозированная.
У больных с
поражением слизистой оболочки рта микоз часто распространяется на углы рта – развивается кандидоз углов рта.Слайд 74диагностика
При микроскопии нативных или окрашенных анилиновым красителем препаратов при кандидозе
обнаруживают в большом количестве почкующиеся клетки, псевдомицелий или истинный мицелий.
Слайд 75Лабораторная диагностика
осложнена тем, что структура грибков значительно меняется в зависимости
от условий культивирования (среды, температуры, доступа воздуха), с чем связана
способность грибка переходить от паразитарной формы к сапрофитной.Слайд 76Микробиологическое исследование
Микроскопическое
Культуральное
Если получены нечеткие результаты при микроскопии нативных мазков, исследуют
препараты, фиксированные над пламенем или в 95° спирте и окрашенные
по Граму, Романовскому — Гимзе, Цилю — Нельсену, Аравийскому, Хочкиссу — Мак-Манусу и др. С помощью иммерсионной системы относительно легко обнаруживаются друзы, бластоспоры, мицелий грибков.Слайд 79Культуральный метод
Для выделения грибковых культур являются жидкое сусло, сусло-агар,
среда Сабуро.
Для выделения и идентификации дрожжеподобных грибков используют картофельно-морковную
среду, рисовый агар, кукурузную среду и др.Избирательными средами для плесневых грибков являются среда Чапека, картофельно-глюкозный агар, желатиновая среда.
Слайд 82
Культуры грибков исследуют в динамике, определяя цвет, величину, характер поверхности,
рисунок, консистенцию, темп роста, ферментную активность, патогенность. Посевы исследуемых биосубстратов
проводят 2 или 3 раза.Для идентификации культур грибков применяют метод флюоресценции, реакцию иммунодиффузии в геле и др.
Слайд 83предрасполагающие факторы:
иммунодефицитное состояние,
болезнь крови,
новообразование
дисбактериоз кишечника, и др.
Слайд 84Глубокие микозы
Грибы, вызывающие глубокие микозы, диморфные:
во внешней среде они
существуют в виде мицелия,
а в очагах поражения – в
паразитарной (тканевой) форме, которая по морфологии резко отличается от мицелиальной формы. Кроме кожи, глубокие микозы поражают внутренние органы.Слайд 86
К опасным глубоким микозам, вызывающим тяжелые поражения кожи, слизистых-
кокцидиоидоз
гистоплазмоз,
Слайд 87диагностика
Наиболее информативны положительные результаты нескольких серологических реакций одновременно.
Многие возбудители глубоких
М. трансформируются в организме хозяина из сапрофитной формы в тканевую.
В связи с этим в первые недели заболевания иммунные реакции следует ставить с антигенами, полученными из мицелия грибка, в последующие — из его тканевых форм.Слайд 88Актиномикоз
Болезнь вызывается несколькими видами актиномицетов.
Наряду с кожей могут поражаться
внутренние органы.
Более чем у половины пациентов встречается шейно-лицевая форма
кожного актиномикоза, которая проявляется гуммозно-узловатыми, бугорково-уплотненными, атероматозными, абсцедирующими и язвенными высыпаниями.В лечении длительно используют высокие дозы пенициллина и актинолизат.
Слайд 89диагностика
Для выделения анаэробных лучистых грибков (актиномицетов) используется полужидкий (0,3%) мясопептонный
агар с добавлением 1% глюкозы в анаэростате или под слоем
(не менее 1 см) вазелинового масла,тиоглеколевая среда, среда Китта — Тароцци. Питательной средой для анаэробных актиномицетов является 2% мясопептонный агар.
Слайд 91лечение микозов
Самостоятельное лечение микозов крайне нежелательно и опасно. Можно проконсультироваться
у врачей-микологов, которые являются специалистами по инфекционным грибковым заболеваниям.
Слайд 93Профилактика
осторожно разбирать старые и ветхие строения;
проявлять осторожность при работе с
залежалыми стройматериалами;
избегать контакта с грибами на деревьях – они представляют
особую опасность, и после контакта может потребоваться лечение микозов;тщательно проверять продукты на наличие плесени;
Слайд 94выводы
Микозы (грибковые заболевания) – обширная группа поражений кожных покровов, вызываемых
патогенными грибами.
Современные классификации дерматомикозов основаны на родовой и видовой
принадлежности грибов, глубине их проникновения в пораженные ткани (волосы, ногти), преимущественной локализации микоза.Слайд 95
Особо патогенны для человека облигатно-патогенные грибы, которые играют большую роль
в развитии микозов (22 вида трихофитонов, 16 видов микроспорумов и
1 вид эпидермофитона).Тяжесть течения зависит от степени распространенности и состояния реактивности организма больного.